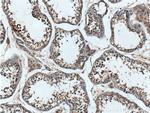
DDR1 Antibody in Immunohistochemistry (Paraffin) (IHC (P))

Search
Proteintech
DDR1 Polyclonal Antibody
{{$productOrderCtrl.translations['antibody.pdp.commerceCard.promotion.promotions']}}
{{$productOrderCtrl.translations['antibody.pdp.commerceCard.promotion.viewpromo']}}
{{$productOrderCtrl.translations['antibody.pdp.commerceCard.promotion.promocode']}}: {{promo.promoCode}} {{promo.promoTitle}} {{promo.promoDescription}}. {{$productOrderCtrl.translations['antibody.pdp.commerceCard.promotion.learnmore']}}
产品信息
10536-1-AP
种属反应
已发表种属
宿主/亚型
分类
类型
抗原
偶联物
形式
浓度
规格
纯化类型
保存液
内含物
保存条件
运输条件
产品详细信息
Immunogen sequence: EALSSLLLL LLVASGDADM KGHFDPAKCR YALGMQDRTI PDSDISASSS WSDSTAARHS RLESSDGDGA WCPAGSVFPK EEEYLQVDLQ RLHLVALVGT QGRHAGGLGK EFSRSYRLRY SRDGRRWMGW KDRWGQEVIS GNEDPEGVVL KDLGPPMVAR LVRFYPRADR VMSVCLRVEL YGCLWRDGLL SYTAPVGQTM YLSEAVYLND STYDGHTVGG LQYGGLGQLA DGVVGLDDFR KSQELRVWPG YDYVGWSNHS FSSGYVEMEF EFDRLRAFQA MQVHCNNMHT LGARLPGGVE CRFRRGPAMA WEGEPMRHNL GGNLGDPRAR AVSVPLGGRV ARFLQCRFLF AGPWLLFSEI SFISDVVNNS SPALGGTFPP APWWPPGPPP TNFSSLELEP R (4-403 aa encoded by BC008716)
靶标信息
DDR1 is a receptor tyrosine kinase activated by collagen and is reported to regulate adhesion, cell migration and other cellular processes. Receptor tyrosine kinases (RTKs) play a key role in the communication of cells with their microenvironment. These molecules are involved in the regulation of cell growth, differentiation and metabolism. The protein encoded by this gene is a RTK that is widely expressed in normal and transformed epithelial cells and is activated by various types of collagen. This protein belongs to a subfamily of tyrosine kinase receptors with a homology region to the Dictyostelium discoideum protein discoidin I in their extracellular domain. Its autophosphorylation is achieved by all collagens so far tested (type I to type VI). In situ studies and Northern-blot analysis showed that expression of this encoded protein is restricted to epithelial cells, particularly in the kidney, lung, gastrointestinal tract, and brain. In addition, this protein is significantly over-expressed in several human tumors from breast, ovarian, esophageal, and pediatric brain. This gene is located on chromosome 6p21.3 in proximity to several HLA class I genes. Alternative splicing of this gene results in multiple transcript variants.
仅用于科研。不用于诊断过程。未经明确授权不得转售。
生物信息学
蛋白别名: CD167 antigen-like family member A; CD167a; Cell adhesion kinase; DAAP-278B20.1; DDR1d; Discoidin receptor tyrosine kinase; Epithelial discoidin domain receptor 1; Epithelial discoidin domain-containing receptor 1; HGK2; juxtamembrane region; Mammary carcinoma kinase 10; MCK-10; neuroepithelial tyrosine kinase; neurotrophic tyrosine kinase, receptor, type 4; Protein-tyrosine kinase 3A; Protein-tyrosine kinase RTK-6; PTK3A protein tyrosine kinase 3A; TRK E; Tyrosine kinase DDR; Tyrosine-protein kinase CAK; unnamed protein product
基因别名: CAK; CD167; DDR; DDR1; EDDR1; HGK2; MCK10; NEP; NTRK4; PTK3; PTK3A; RTK6; TRKE
UniProt ID: (Human) Q08345
Entrez Gene ID: (Human) 780